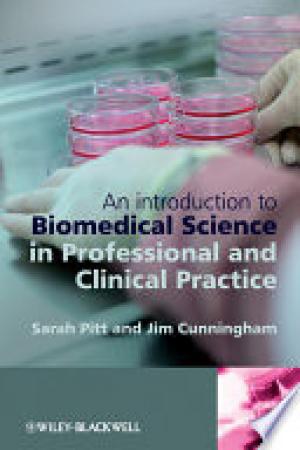
An Introduction to Biomedical Science in Professional and Clinical Practice

Publisher: John Wiley & Sons
Found 144 books in total
2010,
Enzybiotics is a promising way of fighting bacterial or fungal infectious diseases by...
2009,
Fully revised and expanded, Goat Medicine, Second Edition includes discussions on new...
2009,
Published in cooperation with the United States Aquaculture Society A strong...
2007,
A fully revised version of the successful First Edition, this one-stop reference book...
2008,
This third edition of the classic resource, Building Expertise draws on the most...
2008,
Make no mistake, etiquette is as important in business as it is in everyday life —...
2008,
Uncover a digital trail of e-evidence by using the helpful, easy-to-understand...
2007,
The world’s stocks of wild fish continue to decline, making the task of finding...
2008,
Now in its fourth edition, Rational Diagnosis and Treatment: Evidence-Based Clinical...
2008,
You may not believe that there’s a fun and easy way to comply with Sarbanes –Oxley,...
2010,
Traditional agriculture and emerging biofuels technology produce a number of wastes...
2010,
The secrets to reclaiming your personal life and enriching your professional life—for...
2008,
Groundbreaking new research has traced the source of a wide array of to a single...
2010,
Aquaculture Economics and Financing: Management and Analysis provides a detailed and...
2007,
Want to create a compelling Web site for a home business, family, or fun? Whether...
2010,
The best leaders are the best learners. This evidence-based truth has been a...
2007,
In the newly revised second edition of Food Chemistry: A Laboratory Manual, two...
2008,
Horticultural Reviews presents state-of-the-art reviews on topics in horticultural...
2012,
This important book looks at a broad spectrum of biotech research efforts and their...
2008,
This second of two volumes on applications in information technology is divided into...
2008,
In this incisive, concise overview of this booming field, the editors -- two of the...
2009,
Biomedical Science in Professional and Clinical Practice is essential reading for all...
2009,
Fertilizers are key for meeting the world s demands for food, fiber, and fuel....
Books per page: